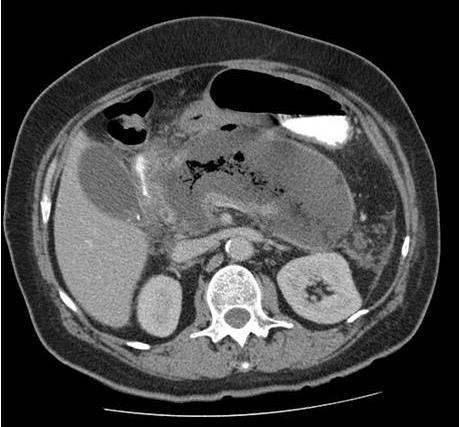
Enunciado 3340357-1

Foram encontradas 2.720 questões.
Homem, 82 anos, hipertenso, diabético, doente renal crônico com taxa de filtração glomerular de 40 mL/min/1,73m2, em uso de metformina 850 mg/dia, insulina NPH 10 UI bedtime, hidroclorotiazida 25 mg/dia e anlodipino 10 mg/dia. Teve diagnóstico recente de osteoartrose de quadril e iniciou uso de inibidor seletivo de COX-2 há dez dias. Há cinco dias, apresenta piora de níveis pressóricos associado a redução de diurese. Comparece para avaliação em bom estado geral, frequência cardíaca 94 batimentos por minuto, frequência respiratória 22 incursões por minuto, pressão arterial 190/128 mmHg, ausculta respiratória com crepitações basais bilaterais, turgência jugular leve a 45 graus e edema de membros inferiores 2/4+. Exames complementares, a seguir:
Ureia 180 mg/dL (prévio 40 mg/dL); Creatinina 4 mg/dL (prévio de 1,7 mg/dL); Potássio sérico 5,2 mEq/L; Sódio sérico 135 mEq/L; Urina tipo 1 sem hematúria, presença de 2 leucócitos por campo e cilindros ausentes.
Assinale a alternativa que apresenta o mecanismo mais provável de lesão renal neste paciente e o sódio urinário esperado em quadros semelhantes.
Provas
Homem, 72 anos, etilista, internado em enfermaria por quadro de pneumonia aspirativa com derrame parapneumônico há 16 dias, fez uso de ceftriaxona e clindamicina por oito dias e atualmente está em uso de piperacilina-tazobactam. Há 48 horas iniciou quadro de dor abdominal e diarreia líquida (seis episódios nas últimas 24 horas). Exames coletados ontem mostram creatinina de 1,2 mg/dL (prévia de 1,0 mg/dL), leucócitos de 8000/mm³ (prévio 9000/mm³), pesquisa de Toxina A e B nas fezes negativa, imunoensaio para antígeno glutamato desidrogenase nas fezes positivo.
Assinale a alternativa que apresenta a conduta mais indicada neste momento e a justificativa adequada para ela.
Provas
Utilize o texto a seguir para responder às questões 74 a 76.
Mulher, 69 anos, portadora de mielofibrose secundária por policitemia vera dá entrada no pronto socorro com quadro de adinamia, fraqueza muscular, sonolência e dispnéia nos últimos seis dias. Nega sangramentos ou febre. Há seis meses tem recebido frequentemente terapia transfusional pela fibrose medular, mas há 40 dias perdeu seguimento no serviço onde era acompanhada. No pronto socorro são realizados os exames abaixo:
Hemoglobina 3,5 g/dL; Hematócrito 12 %; Plaquetas 32000/mm³; Leucócitos 2300/mm³; Presença de dacriócitos.
Optado por transfusão de hemocomponente e cinco minutos após início da terapia, você é chamado para avaliar paciente que refere calafrios, dor lombar importante e sensação de quase morte. Você encontra paciente febril (aumento de 1,5 graus em comparação com temperatura pré-transfusional), frequência cardíaca de 125 batimentos por minuto, pressão arterial de 84/58 mmHg, saturação de oxigênio de 96%, taquipneica, sem lesões urticariformes e sem sibilos, estridores ou estertores à ausculta pulmonar. Assinale a alternativa que apresenta a principal suspeita neste momento e a conduta a ser realizada.
Provas
Utilize o texto a seguir para responder às questões 74 a 76.
Mulher, 69 anos, portadora de mielofibrose secundária por policitemia vera dá entrada no pronto socorro com quadro de adinamia, fraqueza muscular, sonolência e dispnéia nos últimos seis dias. Nega sangramentos ou febre. Há seis meses tem recebido frequentemente terapia transfusional pela fibrose medular, mas há 40 dias perdeu seguimento no serviço onde era acompanhada. No pronto socorro são realizados os exames abaixo:
Hemoglobina 3,5 g/dL; Hematócrito 12 %; Plaquetas 32000/mm³; Leucócitos 2300/mm³; Presença de dacriócitos.
Assinale a alternativa que apresenta qual a melhor conduta transfusional no momento.
Provas
Mulher, 62 anos, comerciante, diabética tipo 2 (não faz uso de insulina), hipertensa e doente renal crônica G2A1 comparece ao ambulatório com queixa de dispneia e dor torácica ao subir escadas ou andar em ladeiras, estável há dois anos. Caracteriza dor como opressiva em região retroesternal e sem irradiação que melhora após três minutos de repouso acompanhada de dispneia não limitante. Foi avaliada em outro serviço onde foram realizados testes não invasivos que traz para consulta. Ao exame físico, pressão arterial 128/72 mmHg, frequência cardíaca 85 batimentos por minuto, frequência respiratória 18 incursões por minuto, ausculta cardíaca e pulmonar normal, sem edemas. Medicações em uso: Losartana 100 mg/dia; Anlodipino 10 mg/dia; Clortalidona 25 mg/dia; Metformina 2550 mg/dia; Saxagliptina 5 mg/dia; Sinvastatina 20 mg/dia.
Laboratório: Hemoglobina 13,3 g/dL; Ureia 48 mg/dL; Creatinina 1 mg/dL; Triglicerídeos 180 mg/dL; HDL-colesterol 48 mg/dL; LDL-colesterol 98 mg/dL.
Teste ergométrico: Negativo para isquemia (frequência cardíaca subótima para o teste).
Ecocardiograma com stress farmacológico:
Em repouso: ventrículo esquerdo com fração ejeção 52% e hipertrofia concêntrica, contratilidade global normal, sem áreas de hipocinesia ou acinesia.
Estresse farmacológico: atinge frequência cardíaca ótima para o exame, hipocinesia transitória em parede inferior basal (um segmento) apenas quando frequência cardíaca acima de 85% da máxima predita com recuperação completa na fase tardia e manutenção de fração de ejeção de 52%.
Quanto ao caso, assinale a alternativa que apresenta a melhor conduta.
Provas
Homem, 48 anos, no nono dia de internação em UTI por quadro de pancreatite aguda necrotizante. No segundo dia, após controle de dor, passou a receber dieta por sonda nasoenteral de forma progressiva e com boa aceitação até o sétimo dia, quando teve recorrência de dor e vômitos, além de três episódios febris em 24 horas e taquicardia sustentada. Atualmente recebendo dieta 1 kcal/mL com volume diário de 1000 mL há dois dias e cinco episódios de vômitos nas últimas 12 horas. Paciente encaminhado hoje para realização de tomografia de abdome com o achado da Figura 11.
Figura 11. Tomografia computadorizada sem contraste de abdome
Tendo em vista a clínica e imagem apresentadas, assinale a alternativa que apresenta qual a hipótese diagnóstica e conduta mais adequada.
Provas
Homem, 28 anos, hígido, conta história de diarreia líquida com sangue, associada a dor abdominal com frequência superior a dez episódios por dia. Já fez uso de albendazol por cinco dias, bem como diversos tratamentos antibióticos, sem melhora do quadro. Não há alterações importantes ao exame físico, exceto o fato dele estar descorado e a presença de dor abdominal leve difusa. Laboratorialmente, as únicas alterações são leve anemia, proteína C reativa 80,3 mg/L (< 5,0 mg/L) e calprotectina fecal quatro vezes acima do valor de referência. Toxinas A e B negativas. Colonoscopia realizada na última semana descreve aspecto de lesões contínuas com perda de haustrações, criptite (microabscessos glandulares) e extensão do cólon ascendente até reto. Ausência de fístulas ou estenoses visualizadas durante o exame. Assinale a alternativa mais adequada para o manejo terapêutico neste momento.
Provas
Mulher, 78 anos, portadora de hipertensão arterial sistêmica, diabetes mellitus tipo 2, doença renal crônica estágio II (creatinina basal 0,8 mg/dL), infarto agudo do miocárdio há dois anos com necessidade de angioplastia e tratamento de infecção urinária por uma Serratia sp. produtora de ESBL (Beta-Lactamase de Espectro Estendido) há seis meses. Refere há dez dias disúria e polaciúria, evoluindo há três dias com lombalgia à direita e febre aferida de 38,2ºC. Dá entrada na sala de emergência confusa, hipotensa, taquicárdica, tempo de enchimento próximo a três segundos, levemente taquipneica, sem desconforto, porém com dor à palpação difusa de abdome, pior em fossa ilíaca direita. Coletadas hemocultura, urocultura e exames séricos na urgência. Você chega para o plantão noturno e o plantonista do dia te mostra a tomografia recém realizada (Figura 10) e refere que não teve tempo de checar os exames laboratoriais ou prescrever antibiótico para a paciente.
Hb 14,0 g/dL; Leucócitos 16.500 mil/mm3 com desvio até metamielócitos; Ureia 102 mg/dL; Cr 1,80 mg/dL; Sódio 139 mEq/L; Potássio 5,1 mEq/L; Bilirrubina Total 1,2 mg/dL; Bilirrubina Indireta 0,20 mg/dL; Bilirrubina Direta 1,0 mg/dL; TGO 45 U/L (< 31 U/L); TGP 40 U/L (< 31 U/L); Gama-GT 32 U/L (5 - 36 U/L); Fosfatase Alcalina 67 U/L (35 - 104 U/L); Albumina 3,7 g/dL (3,4 - 4,8 g/dL); INR 1,1.

Figura 10. Tomografia computadorizada sem contraste de abdome
Assinale a alternativa com a conduta mais adequada para este paciente neste momento.
Provas
Mulher, 34 anos, hígida, com quadro de dor e rigidez matinal superior a uma hora em interfalangeanas distais bilateralmente há seis meses. Na mesma época iniciou prostração intensa e há três meses evoluiu com dor e eritema em tornozelos e ombros. As articulações de mãos começaram a inchar junto. Nega demais sintomas. Traz nessa consulta exames laboratoriais solicitados por outro médico. Ao exame, notam-se edema e eritema em todas as articulações interfalangeanas proximais bilateralmente, bem como edema em tornozelos. Dor à mobilização de tornozelos e ombros.
Hemoglobina 14,0 g/dL; Leucócitos 6.500/mm3; Ureia 23 mg/dL; Creatinina 0,80 mg/dL; Sódio 137 mEq/L; Potássio 4,2 mEq/L; Proteína C Reativa 24,4 mg/L (< 5,0 mg/L); Velocidade de Hemossedimentação 75 mm/hora (< 15 mm/hora); Anti-CCP e Fator Reumatoide pendentes
Além da solicitação de imagens radiográficas, assinale a alternativa mais adequada quanto ao manejo farmacológico.
Provas
Mulher, 70 anos, hipertensa e diabética, ambos de longa data e mal controlados, vem à sua consulta, pois fez um exame de sangue solicitado por outro médico com resultado de creatinina 1,85 mg/dL (ClCr 29 mL/min/1,73 m2) e de ureia 96 mg/dL. Ao exame físico, nada digno de nota, exceto obesidade (peso 96 kg, índice de massa corporal 34 kg/m2). Sob a suspeita de doença renal crônica, você solicita um ultrassom de rins e vias urinárias, além de exames laboratoriais.
Ultrassom de rins e vias urinárias: perda da diferenciação córtico-medular com rins de tamanho pequeno.
Hemoglobina 10,4 g/dL; VCM 92 fL; HCM 28 pg; Reticulócitos corrigidos < 2%; vitamina B12 432 pg/mL (197 - 771 pg/mL); Ácido fólico 14 ng/mL (3,1 - 17,5 ng/mL); Ferro 47 μg/dL (65 - 175 μg/dL); Transferrina 150 mg/dL (200 - 360 mg/dL); Capacidade Total de Ligação de Ferro 204 (228 - 428 μg/dL); Ferritina 504 ng/mL (30 - 400 ng/mL); Índice de saturação de ferro 42% (20 - 40%); Ureia 99 mg/dL; Creatinina 1,80 mg/dL; Sódio 134 mEq/L; Potássio 4,9 mEq/L; Fósforo 7,5 mg/dL (3,5 - 5,5 mg/dL); Cálcio total 10,50 mg/dL (8,40 - 10,20 mg/dL); PTH 53 pg/mL (15 - 65 pg/mL); Gasometria Venosa pH 7,31; HCO3- 18 mmol/L; Saturação de O2 70%; VitD 8,0 ng/mL.
Frente às complicações da doença renal crônica, assinale a alternativa com a conduta mais adequada.
Provas
Caderno Container